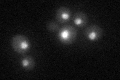
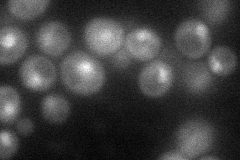
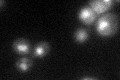
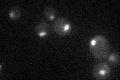

View description
Subunit of the RNA polymerase II mediator complex; associates with core polymerase subunits to form the RNA polymerase II holoenzyme; involved in telomere maintenance; conserved with other metazoan MED31 subunits
Localization:
Intensity:
Fold change:
Significance:
-
C’ GFP library in SD
nucleus35.97 -
N' NOP1pr-GFP in SD
nucleus43.5815 -
N' TEF2pr-mCherry in SD

punctate,nucleus11.3749 -
N' NATIVEpr-GFP in SD

punctate20.4959 -
N' TEF2pr-VC and Cyto-VN in SD

below threshold23.6134 -
C’ GFP library in SD+DTT

nucleus33.660.93No -
C’ GFP library in SD+H2O2
nucleus26.480.73No -
C’ GFP library in Starvation Media
nucleus270.75No -
C’ GFP library on the background of Pup2-DaMP

nucleus -
C’ GFP library on the background of CCT mutant

nucleus25.11890.698201No
